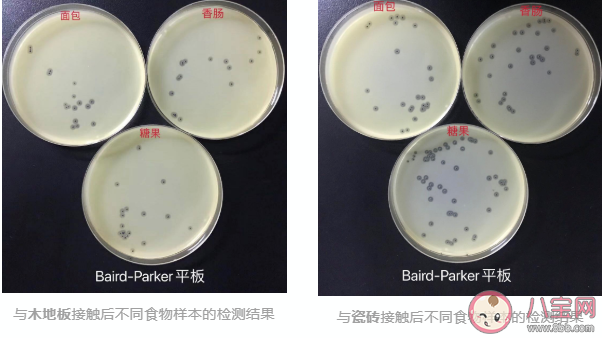
食物掉地上5秒內撿起還能吃嗎 掉地上的食物多久會有細菌 食物掉地上5秒內撿起還能吃嗎 掉地上的食物多久會有細菌

時(shí)間:2021-04-06 14:04:17來(lái)源:本站整理作者:xl點(diǎn)擊:
當(dāng)食物掉落在地上,我們腦海中閃過的是“5秒內(nèi)還能吃”,但通過科學(xué)實(shí)驗(yàn)證明,這種說(shuō)法是比較片面的,不科學(xué)的,掉地上的食物多久會(huì)有細(xì)菌?下面八寶網(wǎng)小編就帶來(lái)介紹。
我們或許都經(jīng)歷過這樣的尷尬場(chǎng)面,手上的食物還沒捏熱乎就“啪嗒”一下掉到了地上,此時(shí)此刻你的內(nèi)心是崩潰且糾結(jié)的。
此時(shí)此刻腦海中閃過一條神秘的傳說(shuō)“五秒法則”,相傳,食物掉在地上只要撿起來(lái)夠快,細(xì)菌還來(lái)不及碰到食物,仍可放心食用。
這個(gè)說(shuō)法廣為流傳事實(shí)果真如此嗎?
專業(yè)技術(shù)人員通過科學(xué)實(shí)驗(yàn)來(lái)向我們展示一系列答案。
step1:
選取常見的食源性致病菌金黃色葡萄球菌為典型污染菌, 選用木地板、瓷磚兩種材質(zhì)模擬地面,經(jīng)121℃,20min高壓滅菌消除本底影響。
step2:
將培養(yǎng)后的金黃色葡萄球菌菌液等量均勻涂布于模擬地面上,保證污染程度基本一致。
step3:
選取常見的并且未檢出金黃色葡萄球菌的面包、香腸、糖果作為食物樣本,將食物樣本與模擬地面進(jìn)行5秒鐘接觸。
step4:
按食品安全國(guó)家標(biāo)準(zhǔn)GB4789.10-2016分別檢測(cè)食物樣本中金黃色葡萄球菌的數(shù)量,比對(duì)不同地面材質(zhì)、不同食物樣本被金黃色葡萄球菌污染的情況。
實(shí)驗(yàn)結(jié)果:
從上面的檢測(cè)結(jié)果可以看出,每個(gè)平皿上都長(zhǎng)了菌落,這表明無(wú)論是木地板還是瓷磚,接觸5秒后,各種食物樣本均受到細(xì)菌污染。因此,食物與地面接觸后,微生物的污染是很快發(fā)生的,快速撿起掉落的食物并不能避免被污染。
“掉到地上的食物與地面接觸時(shí)間越長(zhǎng),被污染程度會(huì)越高嗎?”
技術(shù)人員在之前的實(shí)驗(yàn)基礎(chǔ)上,又增加了10秒、60秒的接觸時(shí)間,再按照之前的實(shí)驗(yàn)方案處理,進(jìn)一步檢測(cè)各種食物樣本中的金黃色葡萄球菌數(shù)量,并對(duì)檢測(cè)結(jié)果進(jìn)行匯總,具體見下表:

實(shí)驗(yàn)結(jié)果表明,香腸、面包、糖果三種食物,分別與木地板、瓷磚接觸5秒、10秒和60秒后,食物中的金黃色葡萄球菌數(shù)量沒有明顯差異,受污染程度基本相同。
綜合以上實(shí)驗(yàn)結(jié)果,“食物掉地上5秒內(nèi)撿起還能吃”的說(shuō)法是片面的、不科學(xué)的,它忽略了那些肉眼看不到的微生物帶來(lái)的潛在威脅,落地食物總是會(huì)不同程度地受到污染。
從保證食品安全和人體健康的角度來(lái)說(shuō),對(duì)于掉落在地上的食物,謹(jǐn)慎的做法還是不要吃。
唐納德模擬了128種食物掉在地上的情形,一共做了2560次實(shí)驗(yàn),并且每一種重復(fù)20次。他在不銹鋼、瓷磚、木頭、地毯四種不同材質(zhì)的表面,分別涂抹上沙門氏菌類似的產(chǎn)氣腸桿菌。
經(jīng)過實(shí)驗(yàn)發(fā)現(xiàn),細(xì)菌的移動(dòng)速度比我們想象得更快,而掉地上食物的細(xì)菌比例多少,與食物本身和地面的材質(zhì)有直接的關(guān)系。假如不同的食物掉在同一種材質(zhì)的地面(如瓷磚),那么在不同時(shí)間,細(xì)菌在不同食物的轉(zhuǎn)移百分比分別是(下圖):

從上圖可以看到,不管是幾秒,只要食物掉地上,細(xì)菌都是瞬間移動(dòng)到食物上。但是從側(cè)面也可以看出,食物的水分含量越高,其被細(xì)菌污染的速度也越快。
相同道理,除了食物的含水量,地面材質(zhì)的密度同樣影響著細(xì)菌污染的比例,細(xì)菌在金屬材質(zhì)的不銹鋼轉(zhuǎn)移速度最快,其次是瓷磚,然后是木頭和地毯。
以上就是有關(guān)全部?jī)?nèi)容介紹,想了解更多信息請(qǐng)繼續(xù)關(guān)注。
網(wǎng)友跟帖
Copyright 2015-2020 8bb.com 〖八寶網(wǎng)〗 版權(quán)所有 鄂ICP備19016373號(hào)-1
聲明: 本站文章均來(lái)自互聯(lián)網(wǎng),不代表本站觀點(diǎn) 如有異議 請(qǐng)與本站聯(lián)系 本站為非贏利性網(wǎng)站 不接受任何贊助和廣告
網(wǎng)友評(píng)論僅供其表達(dá)個(gè)人看法,并不表明八寶網(wǎng)立場(chǎng)。